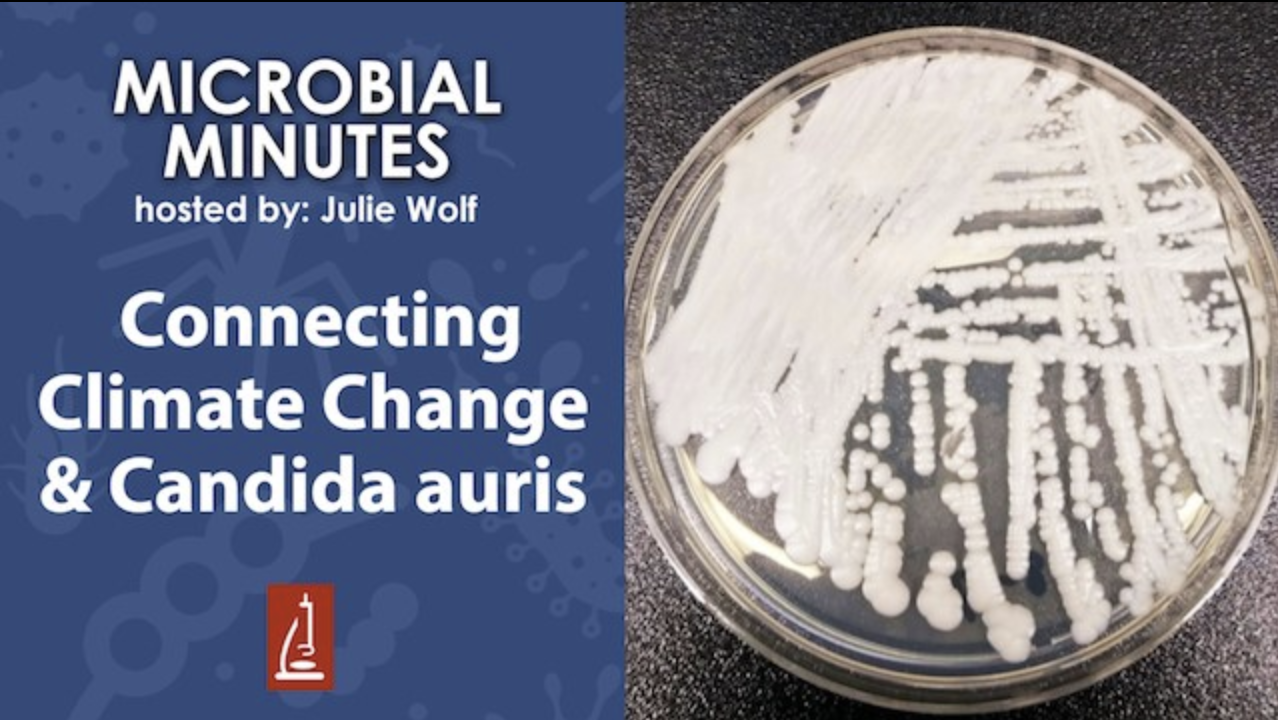

Microbiology and Life Science for Everyone
Video, audio and written content to promote science and the people behind it.
Microbial Minutes YouTube Series
2017-2020
A regularly live-streamed YouTube series highlighting major publications from all fields of microbiology. All streams archived here.
Applied YouTube analytics to evolve the format from biweekly presentations to weekly short-form summaries to better serve audience interest. Created while working at the American Society for Microbiology.

Meet the Microbiologist Podcast Series
Diagnostics in Action: Telling Microbial Stories – Meet the Microbiologist
- Diagnostics in Action: Telling Microbial Stories
- Decoding the Pneumococcal Capsule With Moon Nahm
- From Earth to Orbit: Applied and Environmental Microbiology With Veronica Garcia
- Unraveling Introns and Expectations With Marlene Belfort, Ph.D.
- The Gut Healing Power of Microbes and Cruciferous Vegetables
A regular interview series featuring guests from the microbiology spectrum. Conversations include background context, recent discoveries, and advice for early-career scientists. Each episode ends with a History of Microbiology Tidbit mini-story related to the main conversation. Find the archives here.







Written Articles
Covering scientific discoveries:

Where Do Our Hand Bacteria Come From? ASM website, January 2018.

New Mechanism of Drug Resistance Discovered in Pseudomonas aeruginosa. ASM website, March 2018.

“What’s Hot in the Microbial Sciences?” Microcosm, regular feature 2017-2020.

Essentially E. coli: New Study Identifies E. coli Essential Genes. ASM Website, March 2018.
Covering scientists behind the discoveries:


The Microbial Reasons Why the Impossible Burger Tastes So Good. Microcosm and ASM website, May 2019.

